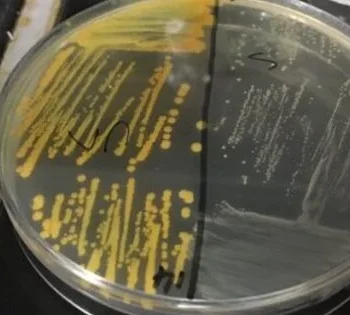

According to a recent study, 87 genes were impacted by deletions or brief insertions throughout the evolution of the mammoth. The scientists point out that
A microbial standoff beneath the prickly spines of European hedgehogs may have bred a dangerous drug-resistant pathogen long before the era of antibiotic use in humans. Antibiotic use, without a
Analysts at the National Institute of Standards and Technology (NIST) have adjusted their iota-based radio collector to identify and show live a variety of TV and computer games. Iota-based interchange
At 6:28 a.m. EDT on August 21, 1972, NASA's Copernicus satellite, the heaviest and most complex space telescope of now is the ideal time, illuminated the sky as it rose
New exploration showed Thursday that the world would save almost 700 million metric tons of carbon contamination every year — more than Canada's yearly outflows — in the event that